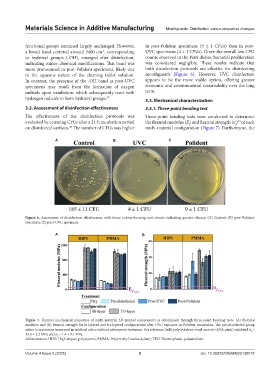

Page 131 - MSAM-4-2
P. 131
Materials Science in Additive Manufacturing Mouthguards: Disinfection versus properties changes
functional groups remained largely unchanged. However, in post-Polident specimens (9 ± 1 CFUs) than in post-
a broad band centered around 3400 cm , corresponding UVC specimens (4 ± 1 CFUs). Given the overall low CFU
-1
to hydroxyl groups (-OH), emerged after disinfection, counts observed in the Petri dishes, bacterial proliferation
indicating minor chemical modifications. This band was was considered negligible. These results indicate that
more pronounced in post-Polident specimens, likely due both disinfection protocols are effective for disinfecting
to the aqueous nature of the cleaning tablet solution. mouthguards (Figure 6). However, UVC disinfection
In contrast, the presence of the -OH band in post-UVC appears to be the more viable option, offering greater
specimens may result from the formation of oxygen economic and environmental sustainability over the long
radicals upon irradiation, which subsequently react with term.
hydrogen radicals to form hydroxyl groups. 47 3.3. Mechanical characterization
3.2. Assessment of disinfection effectiveness 3.3.1. Three-point bending test
The effectiveness of the disinfection protocols was Three-point bending tests were conducted to determine
evaluated by counting CFUs after a 24-h incubation period the flexural modulus (E) and flexural strength (σ ) of each
34
f
f
on disinfected surfaces. The number of CFUs was higher multi-material configuration (Figure 7). Furthermore, the
50
A B C
Figure 6. Assessment of disinfection effectiveness, with lower colony-forming unit counts indicating greater efficacy. (A) Control; (B) post-Polident
specimen; (C) post-UVC specimen
A B
Figure 7. Flexural mechanical properties of multi-material 3D-printed components as determined through three-point bending tests. (A) Flexural
modulus and (B) flexural strength for bi-layered and tri-layered configurations after UVC exposure or Polident immersion. The pre-disinfected group
refers to specimens immersed in artificial saliva without subsequent treatment. For reference, bulk poly(ethylene-vinyl acetate) (EVA; pink) exhibited E =
f
35.8 ± 2.2 MPa and σ = 1.4 ± 0.1 MPa
f
Abbreviations: HIPS: High-impact polystyrene; PMMA: Poly(methyl methacrylate); TPU: Thermoplastic polyurethane
Volume 4 Issue 2 (2025) 8 doi: 10.36922/MSAM025130018